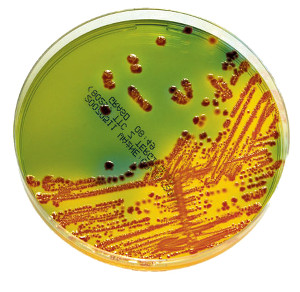
e-coli

Home
The Genomic Epidemiology Ontology (GenEpiO) project aims to develop a more comprehensive controlled vocabulary for infectious disease surveillance and outbreak investigations. Recognizing that GenEpiO encompasses many domains, we have formed a GenEpiO consortium for enhancing its content via interested parties that need particular domain terminology. The consortium currently involves over 70 researchers from 15 countries – if you are interested in this, you are encouraged to get involved.
The ontology files themselves are hosted at https://github.com/genepio/genepio. The FAQ explains how to view and/or request ontology terms. You can also view an introductory slideshow.
We would like to acknowledge the support of the following agencies for enabling the design and development of GenEpiO.